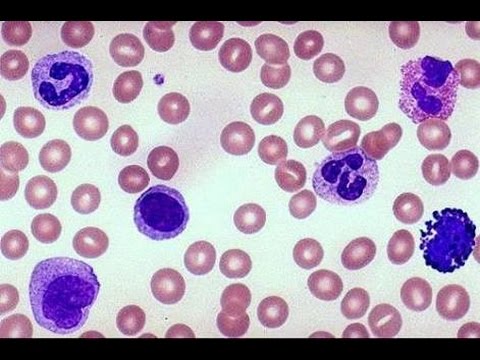

DLC (Differential Leukocyte Count)
4.6 (5 reviews)A blood test that measures the percentage of different types of white blood cells.
Test Details
Also Known As
Differential WBC Count, Differential Leukocyte Count Test, White Blood Cell Differential, DLC Blood Test
Sample Type
Blood
Gender
Male, Female
Age Group
All Ages
Categories
Pathology
Test Code
W B-ED TA (3 ml)
The Differential Leukocyte Count test measures the percentage of each type of leukocyte or white blood cell (WBC) in the blood. This test is a key indicator of WBC abnormalities, such as infections, inflammation, allergies, bone marrow disorders, or autoimmune diseases.
A healthy person's DLC count should fall within a certain range: Neutrophils 40-60%, Lymphocytes 20-40%, Monocyte 2-8%, Eosinophil 1-4% and Basophil up to 1%.
Increased or decreased DLC can also indicate possibility of health conditions of the immune system, autoimmune disorders, and cancers where the body attacks its own cells of the immune system. The normal range of total Leukocyte count (TLC) is 4000 to 11,000 cells/ cubic millimetre of blood.
Recommended Tests

₹69.00 ₹200.00

₹69.00 ₹200.00

₹399.00 ₹800.00

₹299.00 ₹400.00

₹299.00 ₹600.00

₹399.00 ₹800.00

₹79.00 ₹200.00

₹1350.00 ₹2500.00

₹699.00 ₹1500.00